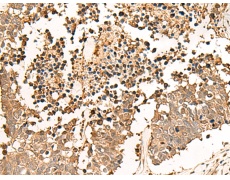
一抗

技術(shù)規(guī)格
Background:
The protein encoded by this gene catalyzes the conversion of L-lactate and NAD to pyruvate and NADH in the final step of anaerobic glycolysis. The protein is found predominantly in muscle tissue and belongs to the lactate dehydrogenase family. Mutations in this gene have been linked to exertional myoglobinuria. Multiple transcript variants encoding different isoforms have been found for this gene. The human genome contains several non-transcribed pseudogenes of this gene.
Applications:
ELISA, WB, IHC
Name of antibody:
LDHA
Immunogen:
Synthetic peptide of human LDHA
Full name:
lactate dehydrogenase A
Synonyms:
LDHM; GSD11; PIG19; HEL-S-133P
SwissProt:
P00338
ELISA Recommended dilution:
5000-10000
IHC positive control:
Human esophagus cancer and Human lung cancer
IHC Recommend dilution:
30-150
WB Predicted band size:
37 kDa
WB Positive control:
Hela, 231, Jurkat, NIH/3T3, 293T and A375 cell lysates
WB Recommended dilution:
500-2000



 購物車
購物車 幫助
幫助
 021-54845833/15800441009
021-54845833/15800441009